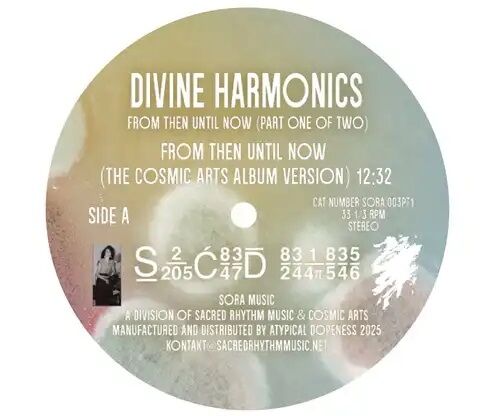
b95da735.jpg

マイストア
変更
お店で受け取る
(送料無料)
配送する
納期目安:
2026.05.27 14:38頃のお届け予定です。
決済方法が、クレジット、代金引換の場合に限ります。その他の決済方法の場合はこちらをご確認ください。
※土・日・祝日の注文の場合や在庫状況によって、商品のお届けにお時間をいただく場合がございます。
ヴェルディの傑作歌劇・輸入盤LP4組(LP12枚) 4/5(土)邦楽廃盤レコードセール 7インチ編 ※4/14(月)通販ボタンの詳細情報
4/5(土)邦楽廃盤レコードセール 7インチ編 ※4/14(月)通販ボタン。b95da735.jpg。廃盤中古レコード入荷情報!「小坂忠」70年代の名作がオリジナル。ヴェルディの傑作歌劇の輸入盤LP4組(LP12枚)で、いずれもかねてより名盤として高い評価を得ているものばかりです。中古品入荷情報】4/25(火)シティポップLP盤100枚入荷。目立つキズ・スレ・痛みも無い比較的美品状態です。ビリー・ウッズ&ケニー・セガル『地図』日本特別盤LP 大理石カラー 限定292枚。今では入手極めて困難なアナログ・レコードです。ビートルズBEATLES/YELLOW SUBMARIN/イタリア盤。1 歌劇 椿姫 アントニオ・ヴォットー指揮ミラノ・スカラ座管弦楽団、合唱団 レナータ・スコット、ジャンニ・ライモンディ、エットーレ・バスティアニーニほか出演 独DGオリジナル・ステレオ3枚組2 歌劇 仮面舞踏会 ジャナンドレア・ガヴァツェーニ指揮ミラノ・スカラ座管弦楽団、合唱団 ジャンニ・ポッジ、アントニエッタ・ステルラ、エットーレ・バスティアニーニほか出演独DGオリジナル・ステレオ3枚組3 歌劇 オテロ トゥリオ・セラフィン指揮ローマ歌劇場管弦楽団、合唱団 ジョン・ヴィッカース、ティト・ゴッビ、レオニー・リザネックほか出演 英RCA・Victorオリジナル・ステレオ3枚組4 歌劇 ナブッコ リッカルド・ムーティ指揮フィルハーモニア管弦楽団、アンブロジアン合唱団 マッテオ・マヌグエラ、レナータ・スコット、ニコライ・ギャーロフほか出演 独EMIオリジナル・ステレオ3枚組 以上4組です。Darondo Didn’t I レコード 45 激レア。
ベストセラーランキングです
近くの売り場の商品
カスタマーレビュー
オススメ度 4.8点
現在、7148件のレビューが投稿されています。